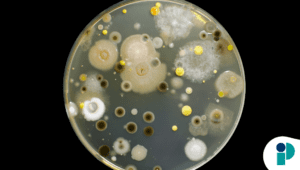
original web (63)

Bacterias vivas en cálculos renales: un hallazgo que cambia lo que se sabía sobre su origen
Durante décadas, la medicina asumió que los cálculos renales se originaban exclusivamente por procesos físico-químicos, como la saturación de minerales en la orina. Sin embargo, un nuevo estudio liderado por